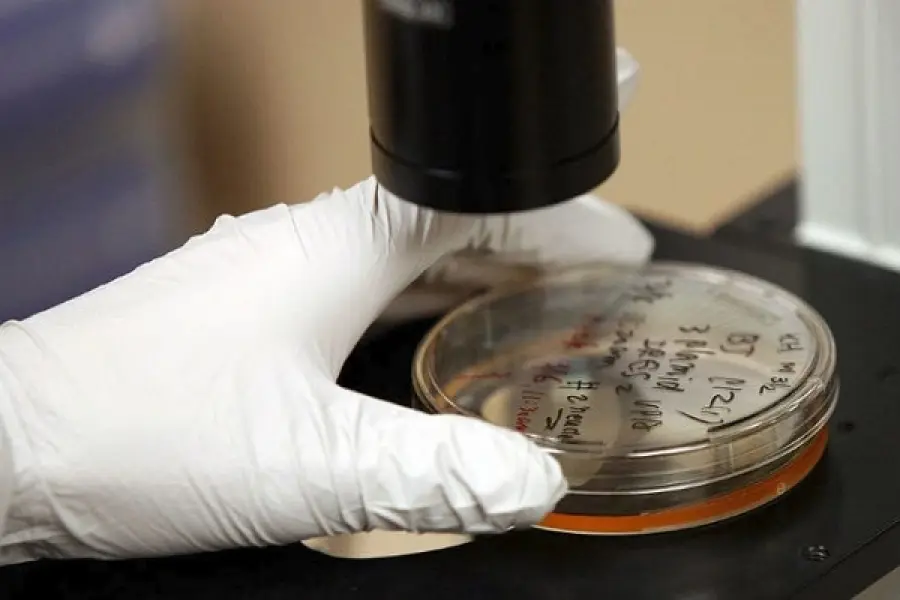
Prevotella, il batterio che cura la sclerosi multipla

Prevotella, il batterio che cura la sclerosi multipla
di Redazione
09/08/2017

E’ presente nella flora batterica intestinale
Straordinaria scoperta a seguito di una ricerca condotta tra Università dell’Iowa e Mayo Clinic e pubblicata sulla rivista Cell Reports: un tipo di batterio della flora intestinale potrebbe essere usato come terapia contro la sclerosi multipla, avviando la medicina verso l’era dei farma-microbi o microbiota, ossia microrganismi usati come un farmaco per curare patologie tipo autismo e Parkinson. In questo caso la Prevotella sarebbe la chiave per sconfiggere la SLA. Una ricerca simile è stata firmata dai ricercatori del San Raffaele di Milano e lo studio pubblicato su Science Advances a luglio.Cos’é la Prevotellae come combatte la sclerosi multipla
La ricerca americana ha dimostrato che i batteri che formano la flora intestinale siano fondamentali per la salute del tratto digerente, ma anche per tutto l’organismo. L’esperimento, chiamato Prevotella Histicola in onore del batterio, consisteva nel far assimilare campioni isolati dalla flora batterica intestinale per via orale ai topi, ai quali era stata indotta l’encefalite allergica sperimentale, simile alla sclerosi multipla. Questa terapia ha fatto effetto: il quadro neurologico dei topini malati era notevolmente migliorato e aumentate le cellule immunitarie. La ricerca riguardo al microbiota è solo agli inizi, ma si è scoperto grazie alle ricerche effettuate che il batterio Prevotella Histicola protegge dallo sviluppo della SLA. Ora, gli scienziati sono concentrati a capire se sia l’assenza di questo batterio intestinale il motivo della malattia, o se un germe o un altro batterio scateni l’insorgere della sclerosi multipla e modifichi, di fatto, il sistema immunitario.Articolo Precedente
Gianluca Vacchi, pignorate ville e barche per 10 milioni di Euro
Articolo Successivo
Immigrazione illegale, avviso di garanzia per Don Mussie Zelai



